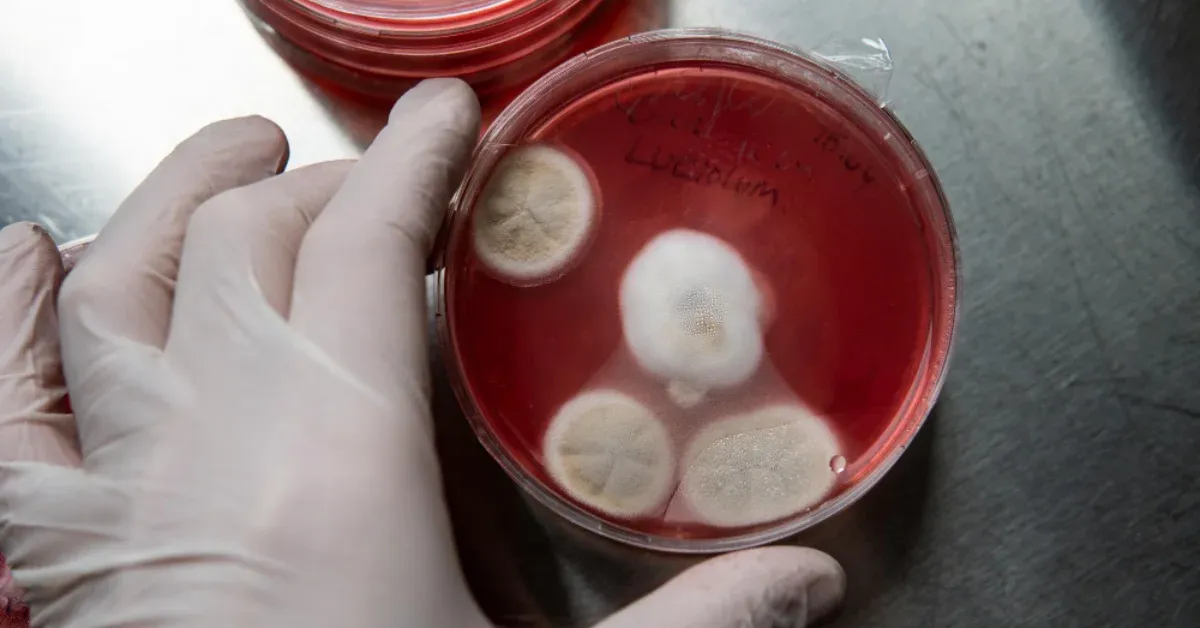
Treatment for Platelet Disorders

You may notice your child bruises more easily than other kids or takes longer to stop bleeding from a small scrape. As a parent, it’s natural to feel concerned and wonder if something more serious could be happening.
You’re not alone—many families have these same worries. One possible explanation could be a platelet disorder. In this guide, we’ll explore what platelet disorders are, what causes them, the signs to look for, and the treatment for platelet disorders that can help children live healthy, active lives.
Platelets are tiny blood cells that play a big role in stopping bleeding. When your child gets a cut, platelets gather at the site, form a plug, and help the blood clot. A platelet disorder happens when there are either too few, too many, or when platelets don’t work the way they should. This imbalance can make it harder for blood to clot, leading to frequent bleeding or bruising.
There are different forms of platelet disorders, and each affects children in unique ways:
Each type requires a different approach to care and treatment of platelet disorders.
Recognizing symptoms early can help with timely diagnosis. Common signs include:
Parents often ask, “What are the symptoms of low platelets?” The most noticeable ones are prolonged bleeding, excessive bruising, and pinpoint spots on the skin.
There isn’t just one cause. Platelet disorders can happen due to several reasons:
Some children are more likely to develop platelet disorders. Risk factors include:
Long-term use of medications that affect platelet function
If platelet disorders are not managed, they can lead to complications such as:
Timely platelet function disorder treatment can help prevent these risks.
Doctors use several steps to find out if a child has a platelet disorder:
Early diagnosis means children can begin the right treatment for platelet disorders quickly.
The treatment for platelet disorders depends on the type and severity of the condition. Common approaches include:
Modern platelet function disorder treatment gives children the ability to enjoy school, play, and family life with fewer restrictions. With today’s medical care, most kids with platelet disorders can live healthy, fulfilling lives.
Platelet disorders may sound overwhelming at first, but with accurate diagnosis and the right treatment of platelet disorders, children can thrive. Parents play a big role in helping kids stay safe and supported, and pediatricians are there to guide families every step of the way.
With early care and proper treatment for platelet disorders, your child’s future can be just as bright and active as any other child’s.
You may notice your child bruises more easily than other kids or takes longer to stop bleeding from a small scrape. As a parent, it’s natural to feel concerned and wonder if something more serious could be happening.
You’re not alone—many families have these same worries. One possible explanation could be a platelet disorder. In this guide, we’ll explore what platelet disorders are, what causes them, the signs to look for, and the treatment for platelet disorders that can help children live healthy, active lives.
What Are Platelet Disorders?
Types of Platelet Disorders
What Are the Symptoms of Platelet Disorders?
What Causes Platelet Disorders?
Risk Factors of Platelet Disorders
What Are the Complications of This Condition?
How Are Platelet Disorders Diagnosed?
How Are Platelet Disorders Treated?
Result
Platelets are tiny blood cells that play a big role in stopping bleeding. When your child gets a cut, platelets gather at the site, form a plug, and help the blood clot. A platelet disorder happens when there are either too few, too many, or when platelets don’t work the way they should. This imbalance can make it harder for blood to clot, leading to frequent bleeding or bruising.
There are different forms of platelet disorders, and each affects children in unique ways:
Each type requires a different approach to care and treatment of platelet disorders.
Recognizing symptoms early can help with timely diagnosis. Common signs include:
Parents often ask, “What are the symptoms of low platelets?” The most noticeable ones are prolonged bleeding, excessive bruising, and pinpoint spots on the skin.
There isn’t just one cause. Platelet disorders can happen due to several reasons:
Some children are more likely to develop platelet disorders. Risk factors include:
Long-term use of medications that affect platelet function
If platelet disorders are not managed, they can lead to complications such as:
Timely platelet function disorder treatment can help prevent these risks.
Doctors use several steps to find out if a child has a platelet disorder:
Early diagnosis means children can begin the right treatment for platelet disorders quickly.
The treatment for platelet disorders depends on the type and severity of the condition. Common approaches include:
Modern platelet function disorder treatment gives children the ability to enjoy school, play, and family life with fewer restrictions. With today’s medical care, most kids with platelet disorders can live healthy, fulfilling lives.
Platelet disorders may sound overwhelming at first, but with accurate diagnosis and the right treatment of platelet disorders, children can thrive. Parents play a big role in helping kids stay safe and supported, and pediatricians are there to guide families every step of the way.
With early care and proper treatment for platelet disorders, your child’s future can be just as bright and active as any other child’s.
Low platelets, or thrombocytopenia, don’t always have a single “cure,” but treatment depends on the cause. Options may include medications, platelet transfusions, or addressing underlying issues like infections or immune conditions. Eating a balanced diet, avoiding alcohol, and regular checkups also help. Always follow your doctor’s guidance for safe and effective management of low platelets.
Several vitamins support healthy platelet production. Vitamin B12 helps bone marrow make platelets, folate supports cell formation, and Vitamin C improves platelet function and absorption of iron. Vitamin D and Vitamin K also play a role in clotting health. Getting these through food or supplements, under medical advice, can support platelet levels naturally.
During pregnancy, mild low platelets can be normal. To support levels, focus on a nutrient-rich diet with foods high in folate, iron, Vitamin C, and B12. Staying hydrated, resting well, and avoiding unnecessary medications are important. Severe cases may require medical treatment or platelet transfusion. Always consult your obstetrician before making dietary or treatment changes.





